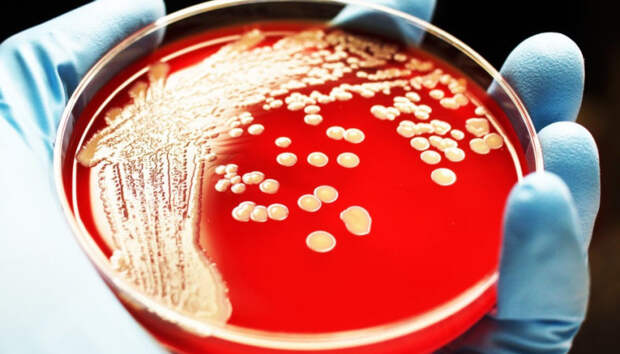

Сельхозпредприятие и ветеринарного врача наказали за неправильное захоронение останков животных Сельхозпредприятие в Олонецком районе захоронило останки туш крупного рогатого скота в землю. Факт выявили сотрудники Россельхознадзора 29 октября. Однако, когда на следующий день, на место прибыли госинспектор отдела пограничного и внутреннего ветеринарного контроля и надзора и ветеринарный врач, то туш не обнаружили.
При этом на […] The post Сибирскую язву искали на «кладбище» рогатого скота в Олонецком районе first appeared on Информационное Агентство 365 дней.
Свежие комментарии